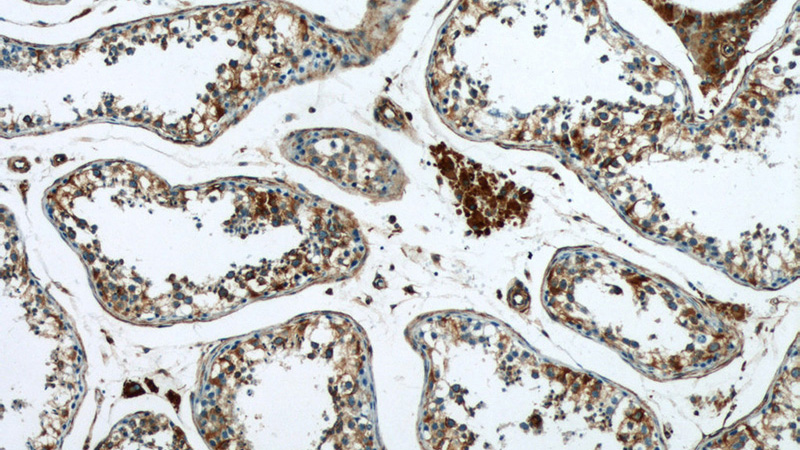
Immunohistochemistry of paraffin-embedded human testis tissue slide using Catalog No:114864(RTN4 Antibody) at dilution of 1:50 (under 10x lens)

-
Product Name
RTN4/NOGO antibody
- Documents
-
Description
RTN4/NOGO Rabbit Polyclonal antibody. Positive WB detected in A375 cells, A549 cells, HepG2 cells, SH-SY5Y cells. Positive IF detected in A375 cells. Positive IHC detected in human testis tissue. Observed molecular weight by Western-blot: 45-50 kDa
-
Tested applications
ELISA, WB, IHC, IF
-
Species reactivity
Human; other species not tested.
-
Alternative names
ASY antibody; FoOCen antibody; KIAA0886 antibody; Nbla00271 antibody; Nbla10545 antibody; Neurite outgrowth inhibitor antibody; NI220/250 antibody; NOGO antibody; NOGO A antibody; Nogo B antibody; Nogo C antibody; Nogo protein antibody; NOGOA antibody; NOGOC antibody; NSP antibody; NSP CL antibody; reticulon 4 antibody; Reticulon 5 antibody; RTN X antibody; RTN4 antibody; RTN4 A antibody; RTN4 B1 antibody; RTN4 B2 antibody; RTN4 C antibody; SP1507 antibody
-
Isotype
Rabbit IgG
-
Preparation
This antibody was obtained by immunization of RTN4/NOGO recombinant protein (Accession Number: NM_153828). Purification method: Antigen affinity purified.
-
Clonality
Polyclonal
-
Formulation
PBS with 0.1% sodium azide and 50% glycerol pH 7.3.
-
Storage instructions
Store at -20℃. DO NOT ALIQUOT
-
Applications
Recommended Dilution:
WB: 1:500-1:5000
IHC: 1:20-1:200
IF: 1:10-1:100
-
Validations

A375 cells were subjected to SDS PAGE followed by western blot with Catalog No:114864(RTN4 antibody) at dilution of 1:1000
Immunohistochemistry of paraffin-embedded human testis tissue slide using Catalog No:114864(RTN4 Antibody) at dilution of 1:50 (under 10x lens)

Immunohistochemistry of paraffin-embedded human testis tissue slide using Catalog No:114864(RTN4 Antibody) at dilution of 1:50 (under 40x lens)

Immunofluorescent analysis of A375 cells using Catalog No:114864(RTN4 Antibody) at dilution of 1:25 and Alexa Fluor 488-congugated AffiniPure Goat Anti-Rabbit IgG(H+L)
-
Background
Reticulon (RTN) proteins are a group of membrane-bound proteins that largely reside in endoplasmic reticulum (ER) (PMID: 18177508). Reticulon proteins share a common sequence feature, the reticulon homology domain (RHD). They are involved in shaping the tubular endoplasmic reticulum network, membrane trafficking, inhibition of axonal growth, and apoptosis (PMID: 24218324). Four mammalian reticulons (RTN1-4) exist. RTN4 (also known as Neurite outgrowth inhibitor or Nogo) is a myelin-associated neurite growth inhibitory protein. There are three isoforms: Nogo-A, Nogo-B, and Nogo-C.
Related Products / Services
Please note: All products are "FOR RESEARCH USE ONLY AND ARE NOT INTENDED FOR DIAGNOSTIC OR THERAPEUTIC USE"
